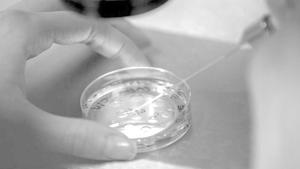

Más leídas

Actualidad | Pág. 2
Centros veraniegos preparan sus piscinas

Cartelera y Tv | Pág. 18
El cascanueces y los cuatro reinos
Chile | Pág. 14
Denuncian las "condiciones insalubres" de caravana migrante

Chile | Pág. 14
May desmiente a Trump y asegura que el Reino Unido y los EE.UU. ya trabajan en un acuerdo post "brexit"

Chile | Pág. 14
Rusia ordena prisión preventiva para 12 marineros ucranianos

Chile | Pág. 14
Siria: exhuman cientos de cadáveres de fosa común en Raqqa

Espectáculos | Pág. 16
Jorge González respecto a su salud: "Fue difícil pero podría haber sido peor"

Espectáculos | Pág. 16
Llega "Viudas", el esperado regreso de Steve McQueen

Espectáculos | Pág. 16
Mega repetirá en su horario estelar "Verdades Ocultas"

Espectáculos | Pág. 16
Paz Bascuñán le responde al abogado de las denunciantes de Nicolás López
Cartelera y Tv | Pág. 18
Animales fantásticos: Los crímenes de Grindelwald

Cartelera y Tv | Pág. 18
Pie pequeño
Chile | Pág. 12
Presupuesto va a Comisión Mixta tras rechazo a recorte en gastos reservados

Servicios | Pág. 20
Controversia mundial y una carta de rechazo causa científico que asegura haber modificado los genes de dos bebés

Servicios | Pág. 20
Los vehículos autónomos pueden impedir los atascos

Deportes | Pág. 21
La ilusión del "Rulo" Álvarez: "Es un sueño jugar una final"

Deportes | Pág. 21
Rodrigo Meléndez y Michael Contreras van al tribunal de la ANFP a buscar "perdonazo"

Deportes | Pág. 21
"Tobby" Castro enciende la definición
Deportes | Pág. 22
Se definieron los horarios de los duelos de la sub 17 y 19 de Cobreloa

Deportes | Pág. 22
Campeones nacionales de vóleibol entrenan en nuestra zona

Deportes | Pág. 22
Gimnasta olímpica dará Master Class en Calama

Deportes | Pág. 22
Final de la Libertadores no se juega en Argentina

Chile | Pág. 14
Canciller turco dice que periodista saudí fue torturado hasta morir

Chile | Pág. 12
Chile y Asia-Pacífico: conectar personas y construir futuro

Actualidad | Pág. 2
Cuando la tristeza se transforma en una posibilidad de emprendimiento y unidad

Actualidad | Pág. 7
Recuperan más de 16 mil kilos de cobre al interior de una parcela

Actualidad | Pág. 2
Se realizó el lanzamiento de la Campaña 27 toneladas de amor

Actualidad | Pág. 4
Hospital de Calama ocupa primer lugar regional en ranking de trato al usuario

Actualidad | Pág. 4
Los partidos políticos de oposición conforman Convergencia Comunal

Actualidad | Pág. 5
Anuncian arreglos en todas las juntas vecinales

Actualidad | Pág. 5
Despidos generalizados tensionan segundo día de movilizaciones de ANEF

Actualidad | Pág. 5
"Invito al intendente a trabajar por extender el Plan Calama"

Actualidad | Pág. 6
Con el apoyo de la comunidad escolar recuperan plazoleta

Actualidad | Pág. 6
Hallan a hombre muerto: es el tercer homicidio en solo un mes

Actualidad | Pág. 6
investigarán los efectos de la altura geográfica en trabajadores

Actualidad | Pág. 7
Sigue intensa búsqueda para ubicar a ingeniero

Chile | Pág. 11
Regresan al país cien chilenos que residían en Venezuela
Opinión | Pág. 8
Frases
Opinión | Pág. 8
Nuestro archivo
Opinión | Pág. 8
Desapariciones que no arrojan resultados

Opinión | Pág. 8
En noviembre

Opinión | Pág. 9
Comentarios en la web
Opinión | Pág. 9
En Twitter: #TwitterEraGenialCuando
Opinión | Pág. 9
Correo

Opinión | Pág. 9
La imagen de la ciudad

Chile | Pág. 10
El juez Carroza celebra la decisión de México de extraditar a Escobar Poblete

Chile | Pág. 10
Los asesores legales de "Emilio" acusan "manipulación" y "persecución política"

Deportes | Pág. 22
Sin Sánchez clasificó el Manchester United